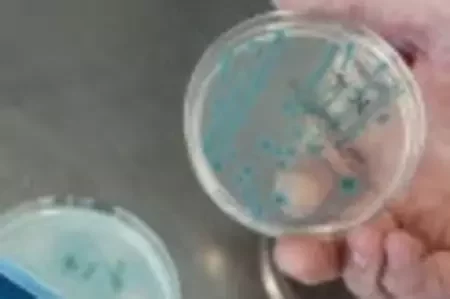

Артыкулы за 20 чэрвеня 2011

Трылер ад Марціновіча пра прыгоды палітэмігранткі з трайным самагубствам аўтара11
Кішачную палачку-забойцу знайшлі ў нямецкім ручаі

Прыбалтыйскія банкі прапануюць даляры па 6,4—14,4 тыс. беларускіх рублёў2

Грэцыя засталася без дапамогі9

Рада ЕС сёння абмяркоўвае новыя санкцыі супраць Беларусі1

Грыбаўскайце: адзін газавы тэрмінал не забяспечыць патрэбаў усіх трох краін Балтыі

Лукашэнка возьме ўдзел у балі Багдановіча6

«Малады Фронт» просіць міністраў ліквідаваць моўную праблему ў турмах7

Растуць продажы машын і абсталявання

Някляеў: «Хай Лукашэнка прабачэння папросіць у палітвязняў, і ўсяго беларускага народа»21

Абама не разлічвае, што стане бацькам трэці раз

У Брэсце адкрыты памятны знак ахвярам Халакосту2

Мядзведзеў не лічыць распад СССР найбольшай геапалітычнай катастрофай XX стагоддзя8

У Беларусі працягвае ўзрастаць аб'ём продажу гарэлкі1

Бабруйск бароніць «Нашу Ніву» і «Народную Волю»2

У Наваполацку затрыманыя тры актывісты аргкамітэта па стварэнні БХД2

Расійскі Першы канал: Беларускія ўлады страцілі пачуцце рэальнасці20

Блогеру Кабанаву падарылі майку «Дружище, ты живешь не по средствам!» - фота5

Цяпер «Наша Ніва» ёсць і Вконтакте. За першыя 30 гадзін набралася 1300 падпісчыкаў34

На выбарах мэра Кішынёва перамагае нацыянал-ліберал, камуністы прайгралі4

Украінская група Femen пікетавала беларускае пасольства ў Кіеве ў падтрымку палітвязняў12

У чарзе на мяжы машыны чакаюць па 30 гадзінаў10
Нас можа чакаць самае моцнае пахаладанне сезона, тэмпература можа апусціцца ніжэй за 30°С

Ілан Маск назваў Радаслава Сікорскага «слінявым ідыётам»

«Настаўніца мыла дошку, пакуль сына білі». Трэцякласніку ў мінскай школе выбілі зубы, маці пайшла ў суд і выйграла

«Толькі тры чалавекі будуць ведаць пра вас. Самы першы чалавек краіны». З'явіліся запісы размоў шпіёнкі Іны Кардаш з куратарам

Загінуў 39‑гадовы зацяты прыхільнік Лукашэнкі — працаваў кладаўшчыком, але падпісваўся як рэжысёр

«Нас гэта мала хвалюе». Эйсмант адказала, што думае пра крымінальную справу супраць Лукашэнкі

Знойдзены Багдан Юнчык расказаў, дзе хаваўся тры дні

Беларуска стала італьянскай кіназоркай і адкрыта выступае супраць дыктатуры Лукашэнкі

больш →